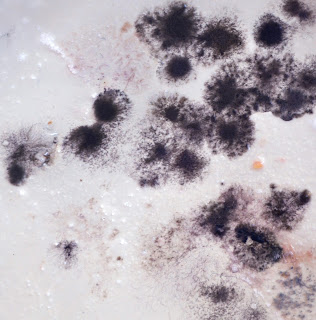

Siguiendo con la comida descompuesta he realizado una serie de fotografías de primer plano de la tapa de un bote en el que el moho crea una serie de formas abstractas y llega a parecerse un cuadro pintado.
jueves, 28 de febrero de 2013
EJERCICIO 16
BODEGÓN
Después de tener una sobre el naturaleza muerta, tuvimos que hacer dos bodegones: uno se trataba de un encargo de un compañero de clase, en el que se describía como debía ser la imagen.
El otro se trataba de un bodegón moderno, y en este caso, el ejercicio era totalmente libre.
Estos fueron los resultados
Bodegón por encargo de Jesús
BODEGÓN
Después de tener una sobre el naturaleza muerta, tuvimos que hacer dos bodegones: uno se trataba de un encargo de un compañero de clase, en el que se describía como debía ser la imagen.
El otro se trataba de un bodegón moderno, y en este caso, el ejercicio era totalmente libre.
Estos fueron los resultados
Bodegón por encargo de Jesús
Bodegón moderno
El para este ejercicio he estado trabajando con comida descompuesta. He guardado durante meses comida en recipientes y he dejado que se pase, para así conseguir texturas y formas atractivas dentro de algo desagradable como es la comida podrida.
Los nuevos planetas:
La obra artística: orientar el precio al coste.
Podemos orientar el precio a lo que nos hayan costado los materiales más la mano de obra: las horas que hayamos echado.
Orientar el precio al mercado
Buscar artistas y conocer su trayectoria.
Tenemos que saber quienes somos y por qué caminos queremos ir.
Hay que estudiar los sitios: galerías, centros de arte, etc. y estudiar qué se hace en estos espacios.
Tienes que saber si quieres ser un artista local, internacional, mediático,...
- El precio de tu obra tiene que ser el mismo en todos los sitios.
- Nunca debe bajar.
- El arte entra dentro del mercado de lujo.
- El arte sirve muchas veces para limpiar dinero negro.
- A veces se hacen descuentos: normalmente el diez por ciento,el cinco por ciento lo hace el galerista y el otro cinco el artista.
- El cliente también pide redondeo.
Pasos a seguir
1- Galería
2- Críticos
3- Instituciones
4- Mercado de las subastas
Lo primero que debemos hacer es preparar un buen dosier e ir a galerías en las que encaje nuestra obra.
Es importante buscar galerías que nos lleven a ferias.
¿Qué influye en el precio de la fotografía?
- Que la obra sea única
- El tamaño, (normalmente como máximo dos tamaños diferentes para una misma fotografía).
- La obra tiene que ir subiendo de precio, nunca bajando.
- Hay que tener algo de orientación de márqueting.
- Se debe hablar con el galerista mucho tiempo y de todos los detalles,(acabado, precios, contratos, etc.).
- NO nos pueden pedir dinero por exponer.
Importante
- Una buena obra.
- Creer en lo que se hace.
- Insistir.
- Buscar apoyos.
- Fijarse en concursos y diferentes posibilidades.
- Encontrar los materiales que se adapten mejor al encargo.
- Organizarse.
PRESUPUESTO-CALIDAD-CREATIVIDAD
vegap
Son una especie de policía de la imagen. Son 60 euros para toda la vida.
Problemas del Vegap: los comisarios y galeristas a veces no quieren que seas del vegap, porque si difunden la imagen en publicidad, etc. tendrían que pagar por eyo. Pero se puede retirar el canon para una determinada exposición. Se les dice que no se les va a cobrar.
Si alguien se apropiara de una imagen tuya, sería muy fácil demostrar que te pertenece, ya que si la has subido a algún blog, página web. etc. por la fecha de subida se demostraría que es tuya.
Siempre decir: YO HE HECHO GRADO Y POSTGRADO CON ESPECIALIDAD.
Podemos orientar el precio a lo que nos hayan costado los materiales más la mano de obra: las horas que hayamos echado.
Orientar el precio al mercado
Buscar artistas y conocer su trayectoria.
Tenemos que saber quienes somos y por qué caminos queremos ir.
Hay que estudiar los sitios: galerías, centros de arte, etc. y estudiar qué se hace en estos espacios.
Tienes que saber si quieres ser un artista local, internacional, mediático,...
- El precio de tu obra tiene que ser el mismo en todos los sitios.
- Nunca debe bajar.
- El arte entra dentro del mercado de lujo.
- El arte sirve muchas veces para limpiar dinero negro.
- A veces se hacen descuentos: normalmente el diez por ciento,el cinco por ciento lo hace el galerista y el otro cinco el artista.
- El cliente también pide redondeo.
Pasos a seguir
1- Galería
2- Críticos
3- Instituciones
4- Mercado de las subastas
Lo primero que debemos hacer es preparar un buen dosier e ir a galerías en las que encaje nuestra obra.
Es importante buscar galerías que nos lleven a ferias.
¿Qué influye en el precio de la fotografía?
- Que la obra sea única
- El tamaño, (normalmente como máximo dos tamaños diferentes para una misma fotografía).
- La obra tiene que ir subiendo de precio, nunca bajando.
- Hay que tener algo de orientación de márqueting.
- Se debe hablar con el galerista mucho tiempo y de todos los detalles,(acabado, precios, contratos, etc.).
- NO nos pueden pedir dinero por exponer.
Importante
- Una buena obra.
- Creer en lo que se hace.
- Insistir.
- Buscar apoyos.
- Fijarse en concursos y diferentes posibilidades.
- Encontrar los materiales que se adapten mejor al encargo.
- Organizarse.
PRESUPUESTO-CALIDAD-CREATIVIDAD
vegap
Son una especie de policía de la imagen. Son 60 euros para toda la vida.
Problemas del Vegap: los comisarios y galeristas a veces no quieren que seas del vegap, porque si difunden la imagen en publicidad, etc. tendrían que pagar por eyo. Pero se puede retirar el canon para una determinada exposición. Se les dice que no se les va a cobrar.
Si alguien se apropiara de una imagen tuya, sería muy fácil demostrar que te pertenece, ya que si la has subido a algún blog, página web. etc. por la fecha de subida se demostraría que es tuya.
Siempre decir: YO HE HECHO GRADO Y POSTGRADO CON ESPECIALIDAD.
Dña. Rosita Copado
Dña. Rosita Copado
tiene una visión muy diferente del arte y la
producción artística, pero no por esto es menos aceptable.
Rosa es una artista que acaba de empezar su
carreta como fotógrafa. Terminó la carrea de Bellas Artes hace cuatro años en CES Felipe II de Aranjuez.
En la charla contaba como para ella
era un honor sentarse delante de todos nosotros para explicarnos su experiencia
al salir de la carrera.
Fue una visita muy agradable y cercana, ya
que creo que la mayoría que la escuchamos pudimos sentirnos identificados con
muchas cosas.
Y de toda la charla me quedo con una frase
que dijo:
martes, 26 de febrero de 2013
PIMA por Alejandro Alcazar Código
ontológico de ELIAC
El galeriasta está para
vender y no para comprar.
Hay que saber tratar con
la otra empresa, y con las personas que la llevan, conocer sus inquietudes y sus
miedos, para que haya una relación fluida.
Una buena comunicación es esencial
-
Pensamiento
global-abstracto
-
Paciencia y
contención
-
Marcar
objetivos y definir trayectos
-
Aprender a
razonar
-
Encontrar
galería es un trabajo difícil.
-
Es importante
no firmar contratos de exclusividad.
-
La
comunicación hay que trabajarla.
-
Medios de
difusión: webs, blogs, dosieres etc.
-
Trabajar por
la calidad del trabajo por encima de todo y con compromiso.
-
Obtención de
avales como formación: premios, becas, etc.
-
Avanzar en tu
formación artística y profesional.
-
Establecer
relaciones y colaboraciones con otros artistas y agentes nacionales e
internacionales.
-
Pensar en
grande, (fuera de España).
-
Pensar en que
el arte también es un negocio. Tenemos nuestra pequeña empresa y generamos un producto.
PRODUCCIÓN, COMUNICACIÓN, VENTA Y FINANZAS
El cuerpo
TAXONOMÍAS
Todas
las imágenes se resumen en estos puntos. A veces se entrelazan, se combinan.
-
Los seres que
se mueven por encima de la tierra
-
Lo que está
quieto encima de la tierra
-
Maquinas,
cosas creadas por el hombre, (no naturales)
-
Abstracciones
geométricas o de mancha
-
Grafismos,
signos y símbolos
El
cuerpo humano ha sido muy representado en la historia del arte, y en occidente
ha sido un tema que se ha tratado muy a menudo.
El
cuerpo es lo que sirve para que nos movamos por la tierra.
El
cuerpo es lo que hace de barrera o límite con el mundo, pero a la vez, es lo
que nos une a él, lo que hace que podamos sentir lo que nos rodea.
El
cuerpo en el arte actual se representa fragmentado, transgredido, prostituido, enfermo,
etc. El objetivo del artista ya no es hacer cuerpos perfectos, son los
cirujanos plásticos los que se encargan ahora de la idealización. Los artistas
nos hemos liberado de todo esto y nos manifestamos. El cuerpo de la mujer cada
vez se parece más a la muerte (delgadez extrema), y el cuerpo del hombre al de
la mujer.
El
arte contemporáneo habla también de la
relación del cuerpo con la tecnología. Queremos cuerpos que se parezcan a las
máquinas. Estamos llegando al hombre cyborg. No queremos cuerpos que desprendan
fluidos, queremos que los cuerpos no huelan, no vomite, que no tenga pelo,
incluso que coma poco, etc.
EXPOSICIÓN 13
Migraciones y racismo
Migraciones y racismo
Migraciones
y racismo es una exposición en la que he participado junto a algunos compañeros de la Universidad, profesores y demás artistas. Está
ubicada en la facultad de Geografía e Historia de Madrid.
Mi
obra, Conversaciones telefónicas en un
locutorio, era una composición de
seis fotografías en las que se recogen grafismos de algunas de las paredes de
las cabinas telefónicas de un locutorio.
La
gente que va al locutorio para hablar por teléfono normalmente es inmigrante, y llega con
intención de hablar con sus familiares y amigos que están lejos.
En
las fotografías se veían reflejados grafismos que se hicieron en esas paredes en
mitad de conversaciones. Podíamos ver en estas imágenes frases escritas como: I love my mum because she’s the best, I need
my family, viva España, etc. También se apreciaban dibujos que nos recuerdan a
las migraciones, como una casa, un camino, un avión, etc. pero también hay
muchas formas abstractas que pueden recordarnos a formas que dibujamos de
manera inconsciente.
Esas
conversaciones, de alguna manera quedaron proyectadas en esas paredes.
De alguna esas conversaciones están proyectadas
y recogidas en estas fotografías.
EXPOSICIÓN 17
Virxilio Vieitez
Edificio Telefónica Gran Via
Virxilio Vieitez es un fotógrafo gallego;
La exposición incluye una serie de más de 250 fotografías entre los años 1953 y 1980; La mayoría de fotografías son en blanco y negro, pero también hay series a color.
La exposición incluye una serie de más de 250 fotografías entre los años 1953 y 1980; La mayoría de fotografías son en blanco y negro, pero también hay series a color.
El artista trata temas familiares en esta colección de fotografías.
Destaco las miradas intensas de las fotografías.
Me gustó mucho los temas que trata, y también la manera en la que te translada a otra época.
EJERCICIO 11
POMPEYA, Catrástofe bajo el Vesubio.
Esta exposición nos traslada a la Antigua Roma.
La exposición se compone de más de seiscientas pertenecientes a varios museos.
Muestran obras que permiten conocer la vida cotidiana en la ciudad antes y después de la erupción del Volcán Vesubio.La exposición se compone de más de seiscientas pertenecientes a varios museos.
Entre todas las obras que recoge la exposición destacan las obras “Retratos de una mujer joven”, “Corredor” y “Marco Holconio Rufo”.
Es curioso como pasados tantos años aún se conservan las piezas. Asimismo me parece muy interesante ver obras qeu se realizaron hace tanto tiempo.
EXPOSICIÓN 14
LA ISLA DEL TESORO ARTE BRITÁNICO
Fundación Juan March
Esta exposición muestra un resumen de los grandes artistas británicos entre los siglos XV y XX..
El título de esta exposición hace referencia a la novela del escritor británico Robert Louis Stevenson, al reflejar que la isla tiene un tesoro.
El título de esta exposición hace referencia a la novela del escritor británico Robert Louis Stevenson, al reflejar que la isla tiene un tesoro.
La exposición está compuesta por ciento ochenta obras.
Están realizadas por diferentes técnicas, también se incluyen libros y escritos..
Temas: La revolución y el Barroco, Sociedad y sátira, Paisajes de la mente, Realismo y reacción Modernidad y tradición, Un mundo feliz..
Están realizadas por diferentes técnicas, también se incluyen libros y escritos..
Temas: La revolución y el Barroco, Sociedad y sátira, Paisajes de la mente, Realismo y reacción Modernidad y tradición, Un mundo feliz..
Me ha gustado mucho la distribución en el espacio de esta exposición, así como la variedad de documentos informativos.
EXPOSICIÓN 12
CAIXA FORUM
Cartografias Contemporáneas
Esta exposición abarca muchos artistas del siglo XX y XXI; presentan cartografías que cuestionan sistemas de representación.La exposición muestra cómo artistas han trastornado el lenguaje cartográfico. Los artistas quieren profundizar en el lenguaje propio de cada movimiento e individuo para representar el mundo.Es un ejemplo de las reflexiones de diferentes autores contemporáneos sobre el significado de la representación, sobre su papel dentro del mundo relacionado con el arte.
Galería José Rincón.
Manuel Ayllón,
Inauguración y presentación del libro de artista: ''DE REGRESO''.
En esta exposición podemos observar estampas y dibujos de Manuel Ayllón, los cuales
aparecen paisajes espaciales que hacen referencia a una etapa de un viaje imaginario;
también encontramos una obra en tres dimensiones. Algunas imágenes incluyen un texto
que nos muestra los pensamientos del protagonista de este viaje.
Me parece una exposición recomendada y muy bonita; las imágenes te sumergen en un
ambiente de tranquilidad y relajación.
EXPOSICIÓN 7
Días transparentes
Galería Cámara Oscura de Madrid
Ellen Kooi
La exposición es de fotografía, la artista es procedente de los Paises Bajos.
Las fotografías reflejan la relación del hombre y la naturaleza, de la persona y su entorno.
Por lo que he leído esta artista ha ido evolucionando y en esta exposición hay unas obras de
un alto nivel comparado con lo de antes. Destaca la composición que utiliza y los detalles.
Me gustó sobre todo la estética de fantasía y cuento que reflejan las imágenes.
EXPOSICIÓN 6
"Calma blanca" de Jean-Marc Bustamante
Sala Alcalá, 31
Hasta 18 Noviembre 2012
La obra de este artísta no se clasifica en ninguna temática ya que utiliza fotografía ampliada en un tamaño bastante grande, pintura, escultura e instalaciones.
Me pareció una exposición curiosa y recomendada. De cada exposición aprendes algo y vale la pena ir aunque no sea de tu estilo.
La obra que más me impactó, que no quiere decir que más me gustó; fue la de la jaula con los pájaros. Me pareció interesante pero no creo conveniente y saludable tener a los animales encerrados en las jaulas como "obra".
Sí que se puede decir que durante toda la exposición escuchabas un sonido lejano de pájaros que transmitía serenidad y tranquilidad y junto con la instalación que era todo blanco y limpio; definia muy bien el titulo de la exposición; "Calma blanca".
Como en algunas exposiciones, está prohibido hacer fotografías, pero añado algunas que pude hacer y otras encontradas en internet.
domingo, 24 de febrero de 2013
EXPOSICIÓN 15
ROBERT ADAMS
Museo Nacional Centro de Arte Reina Sofía.
Esta exposición de Robert Adams se centra en el paisaje con una serie de 300 fotografías en
blanco y negro bajo el título de “El lugar dónde vivimos”.
Las fotografías son de poblados de su tierra natal, instantes de las playas y aves migratorias.
blanco y negro bajo el título de “El lugar dónde vivimos”.
Las fotografías son de poblados de su tierra natal, instantes de las playas y aves migratorias.
EXPOSICIÓN 9
Fundación MAPFRE
Jean Paul Gaultier.
Universo de la Moda.
De la calle a las estrellas
La exposición recoge una serie de obras que resumen el recorrido artístico de la artista.
Se compone de fotografías, vídeos, y bocetos acerca de moda, música y cine.
En esta exposición se reconoce a muchos famosos que han llevado ropa de este diseñador, como Almodovar, Nirvana, Madona, Lady Gaga, …
Se compone de fotografías, vídeos, y bocetos acerca de moda, música y cine.
Observamos influencias de otras culturas, sexo, marineros y sirenas. Una de las cosas que más me han llamado la atención es que en sus diversos maniquís hay proyectado caras y alguna de ellas hablan.
No es una exposición que me haya gustado especialmente, pero reconozco que se recoge mucho trabajo y muy bien resuelto.
Retratos
Obras maestras.
Centre Pompidou
Esta exposición es totalmente diferente a la anterior; trata del retrato a través del siglo XIX y XX centrándose en la pintura y la escultura.
A lo largo de la exposición se pueden ver obras de grandes artistas como Picasso, Modigliani, Bacon, Giacometti, Julio González, …
Es una exposición recomendable ya que puedes observar cómo se retrataba y las características que tienen los retratos de esa época.
Suscribirse a:
Comentarios (Atom)

.jpg)











